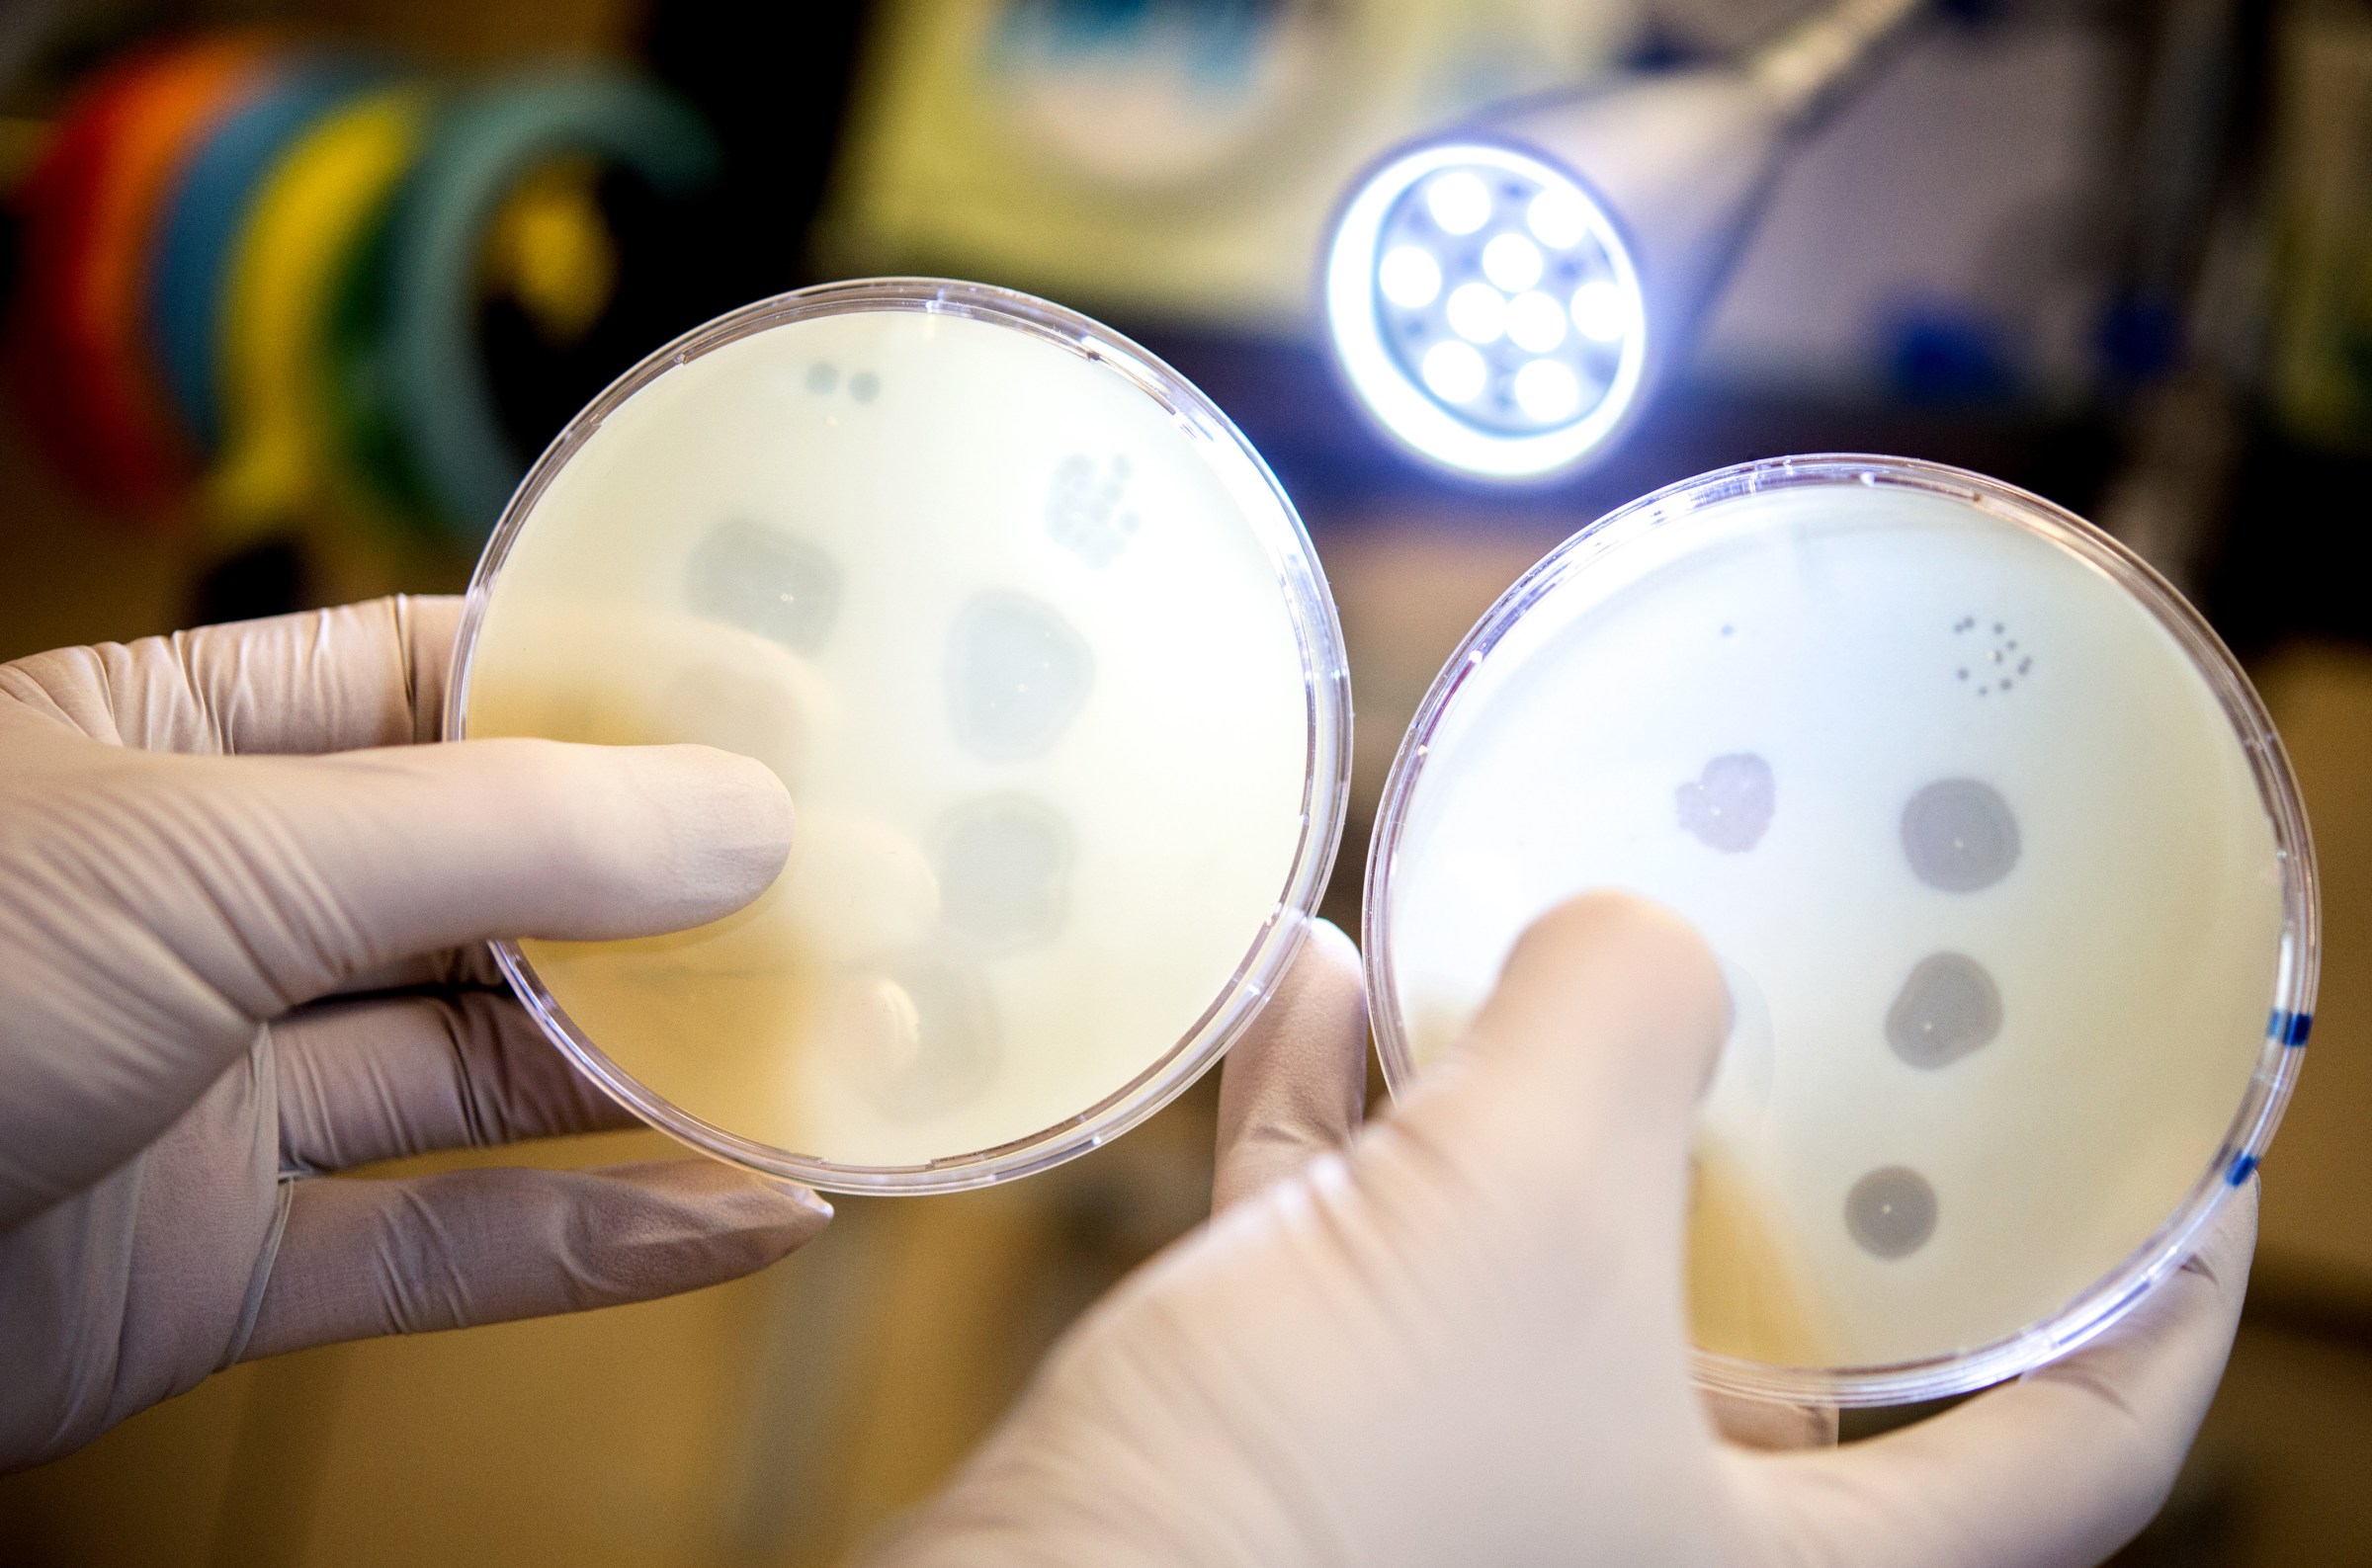

Science
News and updates from the science team. Topics include genetics, infectious disease, psychology, and more.

The troubling ripple effects of more measles outbreaks, explained.

The troubling ripple effects of more measles outbreaks, explained.


Academia runs on underpaid, overworked PhD students. It doesn’t have to.


The confusing guidance about alcohol, simplified.


Five years later, the Covid-19 pandemic has turned people against a cutting-edge medical technology.
The latest in Science


Digital dependence is reshaping our brains. But we can fight it.


How a new asteroid showed Earth’s planetary defense system at work.


The unregulated morass of vitamins and supplements makes it hard to know what’s legitimate. We can help.


The new Health and Human Services secretary is facing one of his first public health crises. Will he blow up the typical protocol?


Some vaccinated people got measles in Texas. Here’s how to check your immunity.

Science depends on animal testing. But the work comes at a steep, hidden cost.


DOGE, please go to sleep. For your health.


And your other urgent sleep questions, answered.


A seemingly small question has shifted how scientists understand the relationship between the brain and the body.


There’s more to bird flu than expensive eggs.


But communities of color face the worst ammonia pollution on the ground, a new study reveals.


Egg donation is common. How well do we understand the risks?




8 things you should know about the number that measures bad air.


Cuts to science spending may save lab animals — at a cost.


Why we won’t cause a mirror bacteria apocalypse — thanks to science.


It turns out cleaning your hands is more complicated than killing germs.


Our earliest studies of Neanderthals were fundamentally flawed.

DMT, “the nuclear bomb of the psychedelic family,” explained.


When you were born is actually an important risk factor for cancer.


We need new malaria drugs — so I spent a year as a guinea pig.

Xenotransplantation raises major moral questions — and not just about the pigs.


Neuroscience is revealing a fascinating link between gratitude and generosity.

Whatever you do, don’t call the Black in Neuro founder “resilient.”


Science should be bipartisan. Why is our confidence split down party lines?

Who owns the escaped monkeys now? It’s more complicated than you might think.


How Musk’s SpaceX became too big to fail for US national security.

This research group is studying our love for haunted houses ... at a haunted house.


Inside the extremely messy, profoundly confusing fight over who should profit from non-human DNA.


What we know — and don’t know — about how global warming influences tropical storms.


What Indigenous knowledge could mean in the fight to curb global warming.


The human mind is designed to predict, but uncertainty helps us thrive.


Scientists are getting better at predicting the sun’s antics.


Billions of dollars later, neuroscientists are still struggling to address the mental health crisis.


(And wait until you hear about Pesto the penguin.)
Bacteria-eating viruses might be able to fight antibiotic resistance where new treatments are most needed.


This storm showed us how mega-storms are worsening. And how unprepared we are.


The mission tested lots of new technology for future, longer missions.


Scientists are trapped in an endless loop of grant applications. How can we set them free?


561 research papers in, the case for degrowth is still weak.
Most Popular
- A new Supreme Court case seeks to revive one of the most dangerous ideas from the Great Depression
- We got rid of acid rain. Now something scarier is falling from the sky.
- This is why Kamala Harris really lost
- Americans’ increasing antisocial habits, explained in one chart
- A new book suggests a path forward for Democrats. The left hates it.